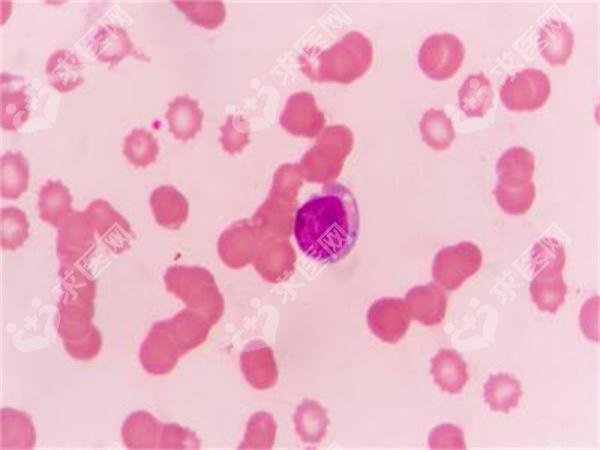

热门搜索

1
试管短方案是一种针对女性卵巢功能较低或年龄较大的患者设计的辅助生殖技术方案。通过科学规划和个体化调整,帮助更多家庭实现孕育宝宝的梦想。在实施过程中,选择较好移植时机至关重要,这不仅关系到胚胎的成功着床率,也直接影响妊娠结果。
在试管短方案中,医生会根据患者的激素水平、卵泡发育情况以及子宫内膜状态,制定个性化的促排卵计划。通常情况下,短方案会缩短药物使用时间,减少对身体的负担。与此同时,通过超声监测与血液检测,精准把握卵泡取出时机,确保获得高质量的卵子。
胚胎移植阶段是整个流程的关键环节。理想的移植时机需要结合子宫内膜厚度、血流状况及患者整体健康状态进行综合评估。一般来说,当子宫内膜达到8-12毫米且形态良好时,被认为是较为适合的时间点。此外,心理状态和生活方式也会影响移植效果,因此建议患者保持轻松心态,避免过度紧张。
为了提高成功率,患者应积极配合医生指导,按时服药并定期复查。同时注意饮食均衡、适度运动以及充足休息,为胚胎着床创造有利条件。通过医患共同努力,试管短方案将为更多家庭带来希望与幸福。

直营医院节省30%的总费用和50%的时间
